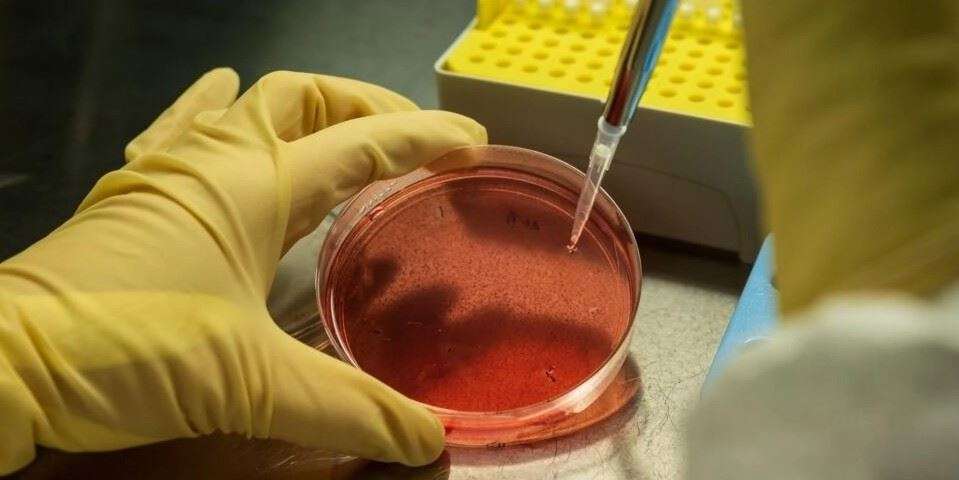

ماذا تعرف عن مقص "كريسبر" الجزيئي؟
وافقت السلطات الصحية الأميركية الجمعة على أول علاج باستخدام مقص "كريسبر" Crispr الجزيئي، وهي تقنية للتحرير الجيني تمثل إنجازا كبيرا في الطب، يُتوقع في هذه الحالة أن تتيح تخفيف معاناة المصابين بمرض نادر في الدم.
في المجمل، جرت الموافقة على علاجين ضد هذا المرض الجيني الوراثي، فقر الدم المنجلي، الذي يصيب حوالي 100 ألف شخص في الولايات المتحدة.
وقال المسؤول الرفيع المستوى في وكالة الأدوية الأميركية (اف دي ايه) بيتر ماركس خلال مؤتمر صحافي "تمثل هذه العلاجات تقدماً كبيراً في مجال العلاج الجيني للمرضى الذين يعانون من فقر الدم المنجلي، وهو مرض دم نادر ومنهك".
وأضاف "إن إمكانات هذه المنتجات لتغيير حياة المرضى الذين يعانون من مرض فقر الدم المنجلي هائلة".
وأكدت الوكالة الأميركية أن هذا المرض يؤثر بشكل خاص على الأميركيين من أصل إفريقي.
وقد خوّل تطوير مقص "كريسبر" الجزيئي الفرنسية إيمانويل شاربنتييه والأميركية جينيفر دودنا الحصول على جائزة نوبل في الكيمياء عام 2020.
وأحدثت هذه التقنية ثورة في معالجة الجينوم من خلال دقتها وسهولة استخدامها مقارنة بالأدوات السابقة.
ويعاني المرضى المصابون بمرض فقر الدم المنجلي من طفرة تؤثر على الهيموغلوبين، وهو بروتين موجود في خلايا الدم الحمراء ينقل الأكسجين إلى أنسجة الجسم. وبسبب هذه الطفرة، تصبح خلايا الدم الحمراء على شكل منجل، ما يحد من تدفق الدم وتوصيل الأكسجين.
ويمكن أن يؤدي ذلك إلى فقر دم مزمن ونوبات مؤلمة للغاية. وقد تكون التداعيات المتصلة خصوصاً بحدوث أضرار في الأعضاء الحيوية، خطيرة، وحتى مميتة.
وبات كلا العلاجين، "كاسجيفي" Casgevy و"ليفجينيا" Lyfgenia، معتمدين من إدارة الغذاء والدواء الأميركية (اف دي ايه) للمرضى الذين تبلغ أعمارهم 12 عاماً وما فوق.
وأشاد الرئيس الأميركي جو بايدن بهذه التراخيص باعتبارها "إنجازاً كبيراً". وقال في بيان "إن هذا التقدم الطبي المهم يُعدّ واعداً جداً لتطوير علاجات أخرى".